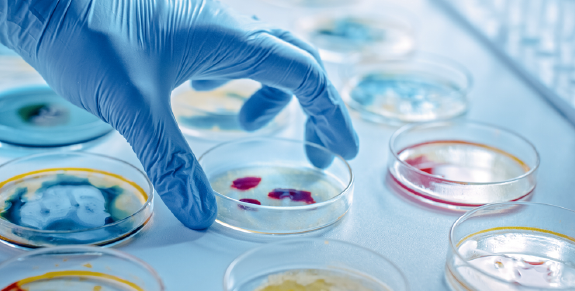

AFIRMA LABS S.C. ofrece servicios analíticos, técnicamente validos operando bajo un Sistema de Gestión de Calidad con base a la NMX-17025-IMNC-2018 que permite integrar todos los requisitos exigibles, tanto legislativos, de clientes y de las normas nacionales e internacionales.















Estos son los servicios que tenemos para tu negocio
Afirma Labs ofrece una amplia variedad de servicios y análisis enfocados en la calidad y seguridad de tus productos.
Análisis de calidad en alimentos

Cursos y/o capacitaciones en línea o presenciales

Declaraciones nutrimentales

Actividad antimicrobiana en desinfectantes

Vidas de anaquel

Residuos tóxicos en alimentos y agua

(metales pesados, pesticidas, antibióticos, etc.)
Análisis de fertilidad de suelos y foliares


Análisis de agua potable NOM 127

Ofrecemos servicios de excelencia, ya que contamos con las acreditaciones necesarias
Estamos comprometidos con la calidad, la mejora continua y el análisis de riesgos para ser más competitivos y ofrecer servicios que cumplan con las exigencias de nuestros clientes, brindando un servicio ético, honesto, confiable, imparcial y transparente.

Nuestra misión es:
ser un laboratorio reconocido nacional en el área de inocuidad alimentaria, agropecuaria y farmacéutica, brindando siempre calidad y rapidez en la entrega de resultados.
Contamos con promociones para tu negocio
Promoción de paquete microbiológico
Análisis rápido 24 hrs. a 48 hrs.
Coliforme fecales
Coliforme totales
E. coli
Salmonela
Estafilococo
Bacterias mesófilas aerobias
Hongos y levaduras
Listeria spp
Promoción de paquete de residuos tóxicos
Pesticidas
Metales pesados
Antibióticos
Aflatoxinas
Migración química
Más análisis

Tablas nutrimentales México NOM-051

Tablas FDA

